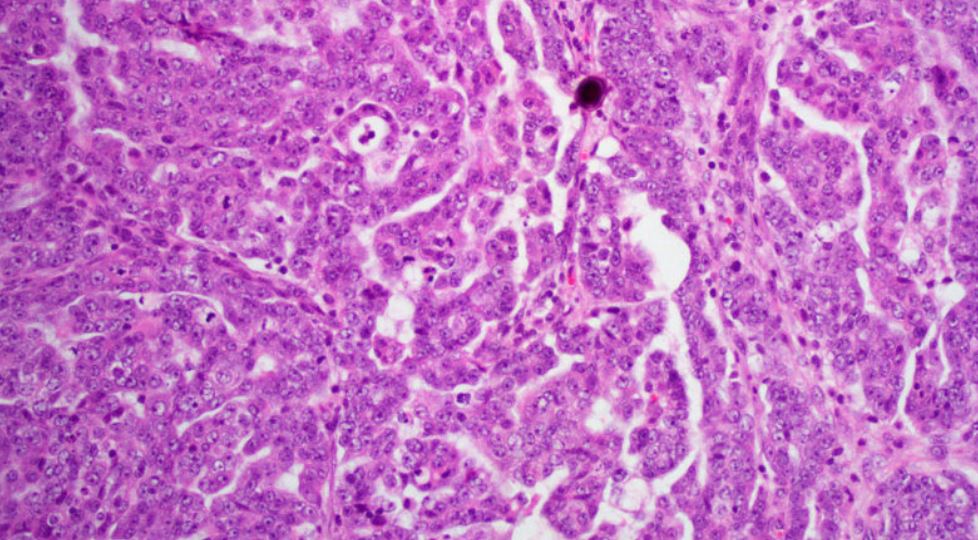

암의 종류과 구분
암의 종류와 구분
암은 '암'이란 단어만 들어도 무섭고 답답합니다. 그만큼 암은 우리에게 공포를 심어주는 존재입니다. 그렇다면 암이 무엇이고, 왜 걸리는 지를 살펴보도록 하겠습니다.
1. 암이란 무엇인가?
암은 한자어로는 癌이렇게, 영어로는 Cancer라는 단어를 사용합니다. 하지만 이러한 단어는 일반인들이 사용하는 단어이고, 암에 대해 조금 깊이 들어가면 종양이라는 단어를 듣게 될 것입니다. 종양은 한마디로 '덩어리'입니다. 종양은 영어로 tumor이란 단어를 사용합니다. 이제 암이라는 단어보다는 종양이란 단어에 익숙해 지시기 바랍니다. 제가 그렇게 쓰겠다는 말이 아니라 개념을 이해하라는 말입니다. 하여튼 두 단어는 교차하면서 사용하겠습니다. 암이든 종양이든 정의를 해보겠습니다.
종양이란 세포가 과잉 증식하여 응어리(종괴)를 형성하는 것이다.
여기서 중요한 것은 '과잉 증식'이란 구절입니다. 종양은 세포입니다. 또한 살아 있는 세포입니다. 문제는 그것이 증식한다는 것입니다. 이것이 문제입니다. 나중에 더 상세히 이야기하고 종양을 구분해 보겠습니다. 종양은 일반종양과 악성 종양으로 구분합니다. 일방 종양은 그냥 종양이라고 말합니다. 악성 종양은 종양이 무한 증식하는 것을 말합니다. 악성 종양을 우리가 편하게 말하는 '암'이라고 부르는 것입니다. 그러니까 악성 종양이 곧 암입니다.
악성종양(암)이란 세포가 무한 증식하는 것이다.
종양과 악성 종양의 차이가 살짝 다릅니다. 과잉이 무한으로 바뀌었습니다. 위의 정의만 보면 암이 하나도 무서워 보이지 않습니다. 그냥 세포가 많아졌을 뿐이다. 라고 생각하기 쉽습니다. 네 틀린 말은 아니지만 암이 정말 무서운 이유는 암세포는 기능성이 없다는 것이고, 다른 세포를 파괴한다는 것입니다. 이것이 무서운 겁니다. 또한 암은 죽지 않습니다. 그래서 무한 증식합니다. 암은 암에 걸린 사람이 죽어야 자신도 죽게 됩니다. 스스로 자멸의 길을 걷는 존재입니다. 결국
암이란 기능성이 사라진 채 무한히 증식하는 세포
입니다. 암은 영원한 존재입니다. 문제는 사람이 영원하지 않으니 영원할 수 없습니다.

암에 걸리는이유와 원리는 아래의 글을 한 번 읽어 보시기 바랍니다. 간단하게 설명해 두었습니다.
기능성이 사라졌다는 말에 주의해 봅시다. 일반적인 세포는 세포가 증식되면서 기능성을 갖습니다. 줄기세포에서 분열된 세포들은 피부가 되기도 하고, 뼈가 되기도 하고, 위가 되기도 하고, 손톱이 되기도 합니다. 그런데 암세포는 이런 기능성이 없습니다. 그냥 세포로만 존재합니다. 그래서 피부에 암에 걸리면 피부의 기능이 사라진 세포들이 피부에 증식합니다. 아래의 사진을 보십시오. 피부암을 찍은 사진들입니다. 이래서 암이 무서운 겁니다.


만약 폐에 암이 걸리면 어떻게 될까요? 산소와 이산화 탄소를 바꾸지를 못합니다. 폐암이 무서운 이유가 여기에 있습니다. 위암에 걸리면요? 네 소화를 시키지 못합니다. 암은 철저히 이기적이고 악랄한 세포입니다. 오직 자기 자신만을 증식하고 확장시키는 존재입니다. 그래서 "넌 암적 존재야"라고 말하면 무서운 욕입니다. 지밖에 모르는 나쁜 놈이란 뜻입니다. 하여튼 여기까지만 하겠습니다. 그러니 암에 걸리지 마십시오. 마음대로 되지는 않지만.
2. 암의 구분
이제 암을 구분해 봅시다. 암의 종류를 찾아보면 100가지가 넘어서 기억도 못합니다. 보통 우리나라에서 가장 많이 걸리는 10대 암을 보면 위암, 폐암, 대장암, 전린섭암, 간암, 갑상선암, 유방암, 자궁경부암, 방광암들이 있습니다. 매년마다 조금씩 다르지만 대체로 이런 암들입니다. 우리나라 10대 암과 건강검진 대상 암은 아래의 글을 참조 바랍니다.
종양은 상피성 종양과 비상피성 종양으로 나뉩니다. 상피성 종양에서 양성은 유방종과 선종이 있습니다. 유방종과 선종은 암은 아니지만 암과 비스무리합니다. 악성 상피성 종양은 암으로 구분이 됩니다. 편평상피암, 선암, 이행상피암, 소세포암, 대세포암으로 구분됩니다. 비상피성 종양은 양성과 악성으로 구분합니다. 글로 하니 복잡하지만 아래의 그림을 보면 잘 이해가 될 겁니다. 많은 분들이 유방종이나 선종은 암이 아니기 때문에 괜찮다는 생각을 합니다. 물론 아직까지는 암은 아니지만 이미 암처럼 변해 있다는 것을 잊으면 안 됩니다. 극히 조심해야 합니다.

- 암에 걸리는 이유는 이 글로 대체합니다.
3. 암의 증식 시간
암은 절대 하루아침에 걸리지 않습니다. 짧으면 5년 길면 10년 정도를 잡습니다. 하지만 어느 순간 폭발적으로 늘어납니다. 면역 세포가 더 이상 불어나는 암세포를 이기지 못할 때 암세포는 기하급수적으로 늘어납니다. 평상시에 면역력을 높이는 습관을 가져야 합니다. 악성 종양의 크기가 1cm가 될 때 암세포수는 무려 10억 개 정도입니다. 작아 보이지만 엄청난 숫자입니다. 1cm가 중요한 이유는 그보다 작을 때는 어떠한 기기로도 암을 판별하기 힘들기 때문입니다. 판별할 수 없는 것이 아니라 암인지 아닌지 구분하기 쉽지 않다는 것이죠. 어느 정도 사이즈가 될 때 저건 암이다라고 판단하는 것입니다.

자, 생각해봅시다. 만약 10억개의 암이 덩어리(종괴)로 만들어지기까지 단지 그것 하나만 있을까요? 저의 글 '암에 걸리는 이유'를 보시면 일단 암으로 판정을 받게 되면 그 과정 속에서 수많은 암이 존재하고 면역 체계가 붕괴될 상태에 놓여 있다는 것을 말합니다. 건강한 사람들도 하루에 약 5000개 정도의 암세포가 만들어집니다. 하지만 면역세포들에 의해 먹히고 잡혀 없어지게 됩니다. 그런데 어느 순간 면역력이 떨어지는 상태가 되면 급속하게 암세포가 증식하게 됩니다. 우리가 과도한 스트레스를 받거나 다른 일로 체온이 떨어질 때 감기가 오는 것과 같습니다. 암이 1cm까지 되기가 힘든 것이지 그 후로는 순식간에 증식합니다. 그래서 위험한 것이니다. 특히 전이가 잘 되는 유방암은 더욱 조심해야 합니다. 최근 들어 유방암은 암도 아니라라는 이상한 생각들을 하는데 절대 그렇지 않습니다. 유방암은 전이성이 굉장히 높습니다.
암이 일단 발병을 하게 되면 2배가 되는 걸리는 시간은 짧으면 1개월 길면 3개월 정도 소요가 됩니다. 즉 암세포는 우리가 생각하는 것보다 훨씬 빠르게 증식합니다.
암의 증식 방식
1) 파종성
씨앗을 뿌리듯 흩뿌리며 퍼져간다.
2) 팽창성
풍성처럼 한 곳에서 점점 부풀러 오르는 증식 방법이다. 시간이 지나면 뚜렷한 윤곽이 드러나면 주변의 장기들을 파괴시킨다.
3) 침윤성
물이 모래로 스며들듯 주변의 세포나 장기들로 퍼져 나간다. 악성도가 가장 높은 증식방법이다.
4. 암의 전이
암이 무서운 건 전이 때문입니다. 전이는 원래 암이 생성된 곳에서 다른 곳으로 퍼져 나가는 것을 말합니다. 암이 곳곳에 생길 때 원래 어디서 출발했는가를 살핍니다. 이것을 원발성이라 표현합니다. 하여튼 전이가 됨으로서 다른 장기들로 퍼져나갑니다. 암 전이는 혈관과 림프로를 통해 일어납니다.
1) 혈액성 전이
혈관을 통해 전이가 일어남
2) 림프행성 전이
림프관을 통해 전이가 일어남
5. 암의 분류
1) 상피성 종양(epithelial tumor)
상피성은 피부와 관련된 것을 말한다.
(1) 양성 상피성 종양
유두종
선종
(2) 악성 상피성 종양
편평상피암
선암
이행상피암
소세포암, 대세포암
2) 비상피성 종양(non-epithelial tumor)
뼈, 연골, 지방, 근육, 혈관 등을 비상피성이라 말한다.
(1) 연부종양
섬유조직
-양성종양/섬유종, 섬유종증
-악성종양/섬유육종
조직구
-양성종양/ 양성섬유성 조직구종, 피부섬유종, 황색종, 건초거세포증
지방조직
-양성종양/ 지방종
-악성종양/지방육종
근육
-양성종양/평활근종,황문근종
-악성종양/ 평활근육종, 횡문근육종혈관.림프관-악성종양/ 혈광종, 림프관종-악성종양/혈관육종, 림프관육종말초신경-양성종약/ 신경초종, 신경섬유종(증)-악성종양/ 악성 신경초종, 신겸섬유육종
(2) 골 연골 종양골육종연골종
(3) 조혈기, 림프조직 종양혈액암림프종골수종
(4) 멜라닌세포성 종양악생 흑생종
(5) 혼합 종양선편평상피암신아세포증간아세포증기형종
면역의 정의와 면역 관련 용어 해설
면역의 정의와 면역 관련 용어 건강한 생활을 유지하기 위해서는 다양한 건강관련 정보들을 알아야 하지만 그 중심에는 항상 ‘면역’이 자리하고 있습니다. 모든 질병에 관련
e-safety.tistory.com
문서이력
문서발행일 2021-07-16
댓글